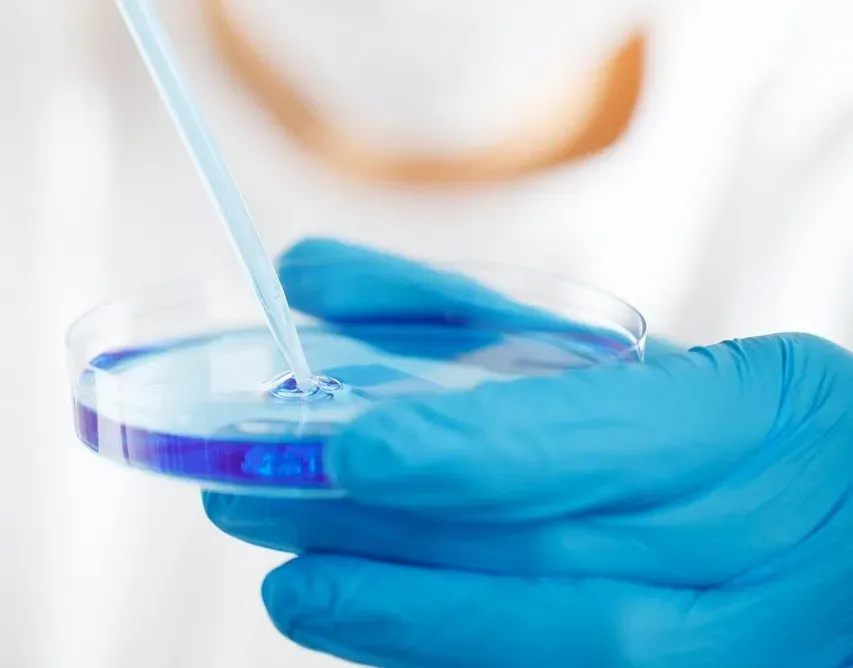
Personalized and Predictive Medicine: Treating Your Version of the Disease (Image Credits: Pixabay)

There’s a quiet revolution happening in hospitals, labs, and even living rooms around the world. Diseases that once felt like life sentences are suddenly being challenged, slowed, or in some cases, almost erased from the body’s story. It doesn’t mean everything is cured or simple now, but the ground under modern medicine is definitely shifting.
Some of these breakthroughs sound like science fiction: editing genes, training the immune system like a special forces unit, printing organs instead of waiting for donors. Others are less flashy but just as powerful, like using artificial intelligence to catch problems before they spiral. Let’s walk through seven breakthroughs that are not just cool headlines, but are genuinely changing how doctors think about, talk about, and treat disease.
Gene Editing: Rewriting the Body’s Instruction Manual

Imagine being able to fix a typo in the body’s genetic code that has caused suffering for generations. That’s what gene editing tools like CRISPR are beginning to do for certain inherited diseases. Instead of only treating symptoms, doctors can now, in some cases, go straight to the root cause: the broken gene itself.
In the last few years, there have been real-world treatments where people with conditions like sickle cell disease have had their own cells edited and given back to them, dramatically reducing their painful crises. It’s not cheap, and it’s definitely not risk-free, but it marks a shift from “managing disease” to “correcting it.” The moral questions are huge – what should we change, and what should we never touch? – but the fact that we’re even asking those questions shows how far we’ve come.
Cell and Gene Therapies: Living Drugs That Keep Working

Traditional drugs usually work only as long as you keep taking them. Cell and gene therapies flip that idea on its head by turning the patient’s own cells into long-lasting treatments. It’s like upgrading your body’s software so it can do new things it couldn’t do before, especially when fighting cancer or rare diseases.
One striking example is CAR-T therapy for certain blood cancers, where a patient’s immune cells are taken out, genetically tweaked to hunt cancer, and then put back into the body. Some people who had run out of options have gone into deep, long-lasting remission after this kind of treatment. The downsides are real – side effects can be intense, and the price tags are massive – but these therapies are forcing healthcare systems to rethink what a “one-time” treatment might mean for lifelong illnesses.
mRNA Vaccines and Beyond: A New Platform for Fighting Disease

Before the COVID-19 pandemic, mRNA technology was mostly a promising idea in labs. Now it’s a proven tool that was used worldwide in record time, and scientists are racing to adapt it far beyond a single virus. Instead of growing viruses in eggs or special cells, mRNA vaccines give the body recipes so it can make harmless pieces of a germ and train the immune system without using the whole pathogen.
This platform approach means that once the basic system is in place, new vaccines against different viruses or even some cancers can be designed and tested more quickly than older methods allowed. Researchers are exploring mRNA shots for flu, RSV, HIV, and personalized cancer vaccines tailored to the mutations in a person’s tumor. It’s not a magic key to every disease, but it’s a flexible toolbox that could speed up how we respond to new threats and stubborn illnesses.
Immunotherapy: Turning the Immune System into a Cancer Hunter

For decades, cancer treatment was mostly surgery, radiation, and chemotherapy, which can be harsh on the body and sometimes miss stubborn cancer cells. Immunotherapy changed the script by helping the immune system see cancer as an enemy again, instead of something to ignore. It’s like taking the blindfold off the body’s natural defenders and pointing them in the right direction.
Checkpoint inhibitors, for example, block the signals that tumors use to hide from immune cells, and they’ve led to long-term survival in some patients with melanoma, lung cancer, and other hard-to-treat cancers. Not everyone responds, and side effects can be complex, because a turned-up immune system can sometimes attack healthy organs too. Still, the idea that your own immune system can learn to control or even eliminate some cancers has reshaped research and given patients a new kind of hope that simply didn’t exist a generation ago.
Artificial Intelligence in Diagnosis: Seeing What Humans Miss

Doctors are skilled, but they’re also human, and humans get tired, overlook subtle patterns, or are limited by how much information they can process at once. Artificial intelligence tools are starting to act like an extra set of highly focused eyes, scanning images, lab results, and medical histories to catch things that might otherwise slip through. It’s not about replacing doctors; it’s about giving them a sharper, faster second opinion.
In fields like radiology and dermatology, AI systems can flag tiny changes in scans or skin images that could indicate early cancer or disease progression, sometimes picking up patterns that have taken years for experts to learn. There are also tools that predict which patients are likely to worsen in the hospital so staff can intervene earlier. The big challenge now is making sure these algorithms are fair, well-tested, and transparent, so they help everyone instead of quietly reinforcing old biases.
Regenerative Medicine and 3D Bioprinting: Repairing Instead of Replacing

For a long time, if an organ failed badly enough, the only real solution was a transplant – if you were lucky enough to find a donor. Regenerative medicine is trying to change that by growing or repairing tissues using stem cells, scaffolds, and even 3D printers that can lay down living cells layer by layer. It sounds wild, but researchers have already created lab-grown skin, cartilage, and simple tissues that can be used in real patients.
3D bioprinting is moving from experimental demos toward practical uses, like printing tissue patches that can help repair damaged hearts or complex structures for studying diseases outside the body. While fully functional printed organs like hearts or kidneys are still a work in progress, the direction is clear: instead of just replacing parts, medicine wants to help the body rebuild them. The idea that your future knee or heart valve might be grown specifically for you is slowly shifting from fantasy to long-term planning.
Personalized and Predictive Medicine: Treating Your Version of the Disease
Two people can have the same diagnosis on paper but very different versions of the disease in real life. Personalized medicine accepts that reality and uses data – genetic tests, lifestyle details, past responses to treatments – to tailor care to the individual rather than following a one-size-fits-all playbook. In cancer care, for instance, labs can analyze a tumor’s unique mutations and match them with targeted drugs that zero in on specific weak spots.
On top of that, predictive tools are being used to estimate who is most at risk of conditions like heart disease, diabetes, or dementia before obvious symptoms appear. That gives people more time to change habits, start medications early, or join monitoring programs instead of waiting for a crisis. It’s a big shift in mindset: from reacting when something goes wrong to quietly adjusting course long before the damage becomes visible.
A Future Where “Incurable” Starts to Lose Its Grip

All these breakthroughs share one big idea: we’re moving away from simply fighting the damage diseases cause and toward changing the disease itself, often at its roots. Gene editing aims to correct faulty instructions, cell therapies install new defenses, AI catches threats earlier, and regenerative medicine tries to rebuild what was lost instead of accepting permanent scars. It doesn’t make illness vanish from human life, but it does change what’s possible when someone hears a diagnosis that once felt like a dead end.
There are still huge barriers: cost, access, ethics, and the slow, cautious pace of testing what we dare to do with the human body. But the door has opened to a world where “nothing more can be done” is said less often, and “let’s try this new approach” is heard more. Looking at these changes, it’s hard not to wonder: which of today’s most feared diseases will be the next to lose its power over us?



